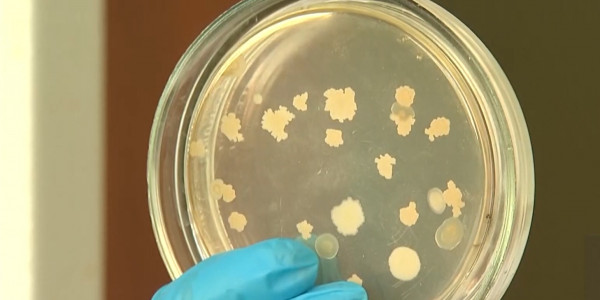
Алматинские учёные получили из бактерии необычный пластик &laquo;псевдомонас&raquo;

Ученые : последние новости
300 млн тенге грантового финансирования от Фонда науки могут получить казахстанские ученые.
Алматинские учёные получили из бактерии необычный пластик. Его синтезирует казахстанский штамм микроорганизма под названием «псевдомонас».
Известный учёный-филолог, академик Серик Кирабаев ушёл из жизни в возрасте 95 лет.
Ученые реконструировали одежду Золотого человека, найденного два года назад в могильнике Таскопа в Темирском районе Актюбинской области.